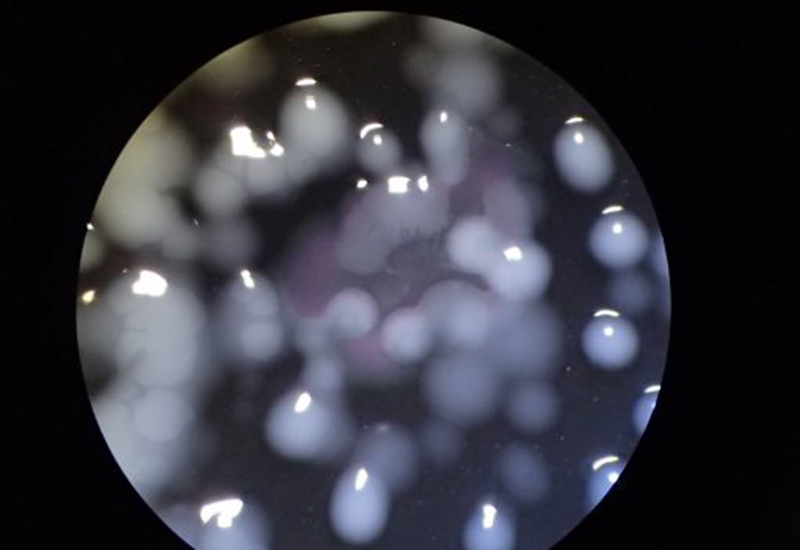

レジオネラ解説記事
発症者の死亡率は15~30%。レジオネラという危険な菌
レジオネラは国内で毎年60名近くの死亡が報告される危険な病原菌です。レジオネラ症の死亡率は15~30%、とくに高齢者や幼児など免疫力が低い方は肺炎を発症しやすく、重症化すると致死率がさらに高まります。抗生物質は有効ですが、発見や治療の遅れは重大なリスクになります。
温泉・浴場施設、冷却塔、クーリングタワー、24時間風呂など、管理が不十分な人工環境で増殖するケースが知られています。
レジオネラ菌のコロニー

レジオネラ菌の単離コロニー

レジオネラ検査の様子
感染経路は?
レジオネラ症は空気感染はしませんが、菌を含む水しぶきやミスト(エアロゾル)を吸入することで感染します。1976年、米国で冷却塔からのエアロゾルが原因の集団感染が発生し、以後、日本でも海外でも集団感染と死亡例が報告されています。
レジオネラが増える場所
レジオネラは川・沼・土壌など身近な自然界に生息します。
砂埃や粉じん、人の出入りで外環境に触れやすい施設では、混入と増殖のリスクがあります。
とくに常時湿っており、土埃が入りやすい環境で増殖しやすいことが知られています。
- アスファルトの水たまり
- シャワーヘッド
- 浴槽水(循環式浴槽など)
- 冷却塔水・クーリングタワー
- 車のウォッシャー液タンク(とくに水で代用時)
- 公園の噴水・親水施設
施設管理者やご家庭の衛生管理担当者は、菌の特性を理解し、日常的に対策と監視(定期検査)を行うことが重要です。
レジオネラ対策
浴場・温泉・冷却塔などの人工環境には、「新版レジオネラ症防止指針」等に基づく対策が定められています。塩素消毒や貯湯・冷却塔の管理、清掃方法、消毒剤の選定、管内に形成されるバイオフィルムの管理など、施設種別ごとの具体策が示されています。
塩素消毒が効きにくい場合がある
レジオネラはアメーバに寄生し、配管内などでバイオフィルムを形成すると、消毒薬が届きにくく塩素が効きにくい場合があります。通常の塩素処理のみでは除去しきれないことがあり、日常的な清掃・バイオフィルム除去が重要です。二酸化塩素の活用も有効とされています。
基準値(目安)
| 対象 | 基準 | 備考 |
|---|---|---|
| 浴槽水・原湯 | 10個(CFU)/100 mL 未満 | 「公衆浴場における水質基準等に関する指針」(厚生労働省) |
| 冷却塔水・クーリングタワー水 | 100個(CFU)/100 mL 未満 | 上記数値超過時は清掃・消毒等を実施し、不検出(10 CFU/100 mL未満)確認後に復帰 |
| 水景施設(噴水・親水施設 等) | 100個(CFU)/100 mL 未満 | 同上 |
※エアロゾルを直接吸引する恐れがあるもの(浴槽水・シャワー水など)は、10 CFU/100 mL未満を目安とし、検出時は清掃・消毒・換水などを実施のうえ不検出の確認が求められます。
公衆浴場の水質検査項目と検査基準
原水・原湯・上り用湯・上り用水
| 項目名 | 基準値 |
|---|---|
| 色度 | 5度以下 |
| 濁度 | 2度以下 |
| pH | 5.8~8.6 |
| 過マンガン酸カリウム消費量 | 10 mg/L以下 |
| 大腸菌群数 | 50 mL中 検出されないこと |
| レジオネラ属菌 | 10 CFU/100 mL未満 |
浴槽水
| 項目名 | 基準値 |
|---|---|
| 濁度 | 5度以下 |
| 過マンガン酸カリウム消費量 | 10 mg/L以下 |
| 大腸菌群数 | 1 個/mL以下 |
| レジオネラ属菌 | 10 CFU/100 mL未満 |
※自治体により条例で別基準が定められている場合があります。
検査頻度
レジオネラは目視での確認ができないため、施設種別・利用形態に応じて定期的な監視(検査)が必要です。以下は目安です(自治体の条例や施設内規程がある場合はそちらを優先)。
| 対象 | 主な検査項目 | 頻度(目安) | 備考 |
|---|---|---|---|
| 浴槽水(循環式含む) | レジオネラ属菌/大腸菌群/濁度 等 | 年1回以上 | 条例で回数追加や項目追加が定められる場合あり。 |
| 原湯・原水・上り用湯/上り用水 | 色度/濁度/pH/有機物/大腸菌群/レジオネラ | 年1回以上 | 厚生労働省「公衆浴場における水質基準等に関する指針」を参照。 |
| 冷却塔水・クーリングタワー水 | レジオネラ属菌 | 年1回以上 | 基準超過時は清掃・消毒等を実施し、不検出を確認して復帰。 |
| 水景施設(噴水・親水施設 等) | レジオネラ属菌 | 年1回以上 | エアロゾル曝露リスクがある場合は特に監視強化。 |
※基準の考え方の概要:エアロゾルを直接吸入する可能性が高い系(浴槽水・シャワー水など)は厳格(不検出相当の管理)とし、それ以外の人工環境水は100 CFU/100mL未満を目安に管理します。超過時は清掃・消毒・換水等の改善後に不検出(10 CFU/100mL未満)の再確認を行います。
検査料金・お申し込み
ご利用方法は郵送検査(採水キット)と、技術員による現地採水の2方式に対応しています。必要項目・施設形態・自治体の求める書式に合わせてプランをご提案します。
- 郵送検査:採水キットをお届け → 採水 → 返送 → 試験 → 結果報告(PDF/紙)
- 現地採水:技術員が訪問し、規定手順で採水・搬送を実施
- 追加対応:基準超過時の再検査、原因の推定、対策の助言(必要に応じて)
詳しい検査項目内容について
検査は、施設種別ごとの必要項目に合わせて構成します。下記はよく利用される主な項目です(施設・条例により変動)。
- レジオネラ属菌(培養法)
- 大腸菌群(一般細菌を含む衛生指標)
- 濁度・色度・pH
- 有機物(TOC または 過マンガン酸カリウム消費量)
- 冷却塔水:レジオネラ属菌(必要により一般細菌等)
- 水景施設・親水施設:レジオネラ属菌
- 必要に応じて残留塩素・導電率など管理指標
陽性対応
基準を超過した場合は、直ちに使用中止/系統の清掃・消毒/換水・ろ過器洗浄等を実施し、改善後に再検査を行います。バイオフィルムの除去や、消毒剤(例:二酸化塩素)の選定・管理手順の見直しも有効です。
- 超過の原因が推定される箇所(配管・循環系・冷却塔)の洗浄・消毒
- 残留塩素管理や清掃周期の見直し
- 改善後の再検査で不検出(10 CFU/100mL未満)を確認して復帰
レジオネラの遺伝子検査(迅速対応)
従来の培養法に加えて、遺伝子検査(PCR等)により短時間で結果を得る選択肢があります。緊急時の一次スクリーニングや、改善後確認の迅速化に有用です(正式な適否判断には指針・条例の取扱いをご確認ください)。
結果報告はPDF/紙に対応。検査記録は検査日から3年間の保管が推奨されます。